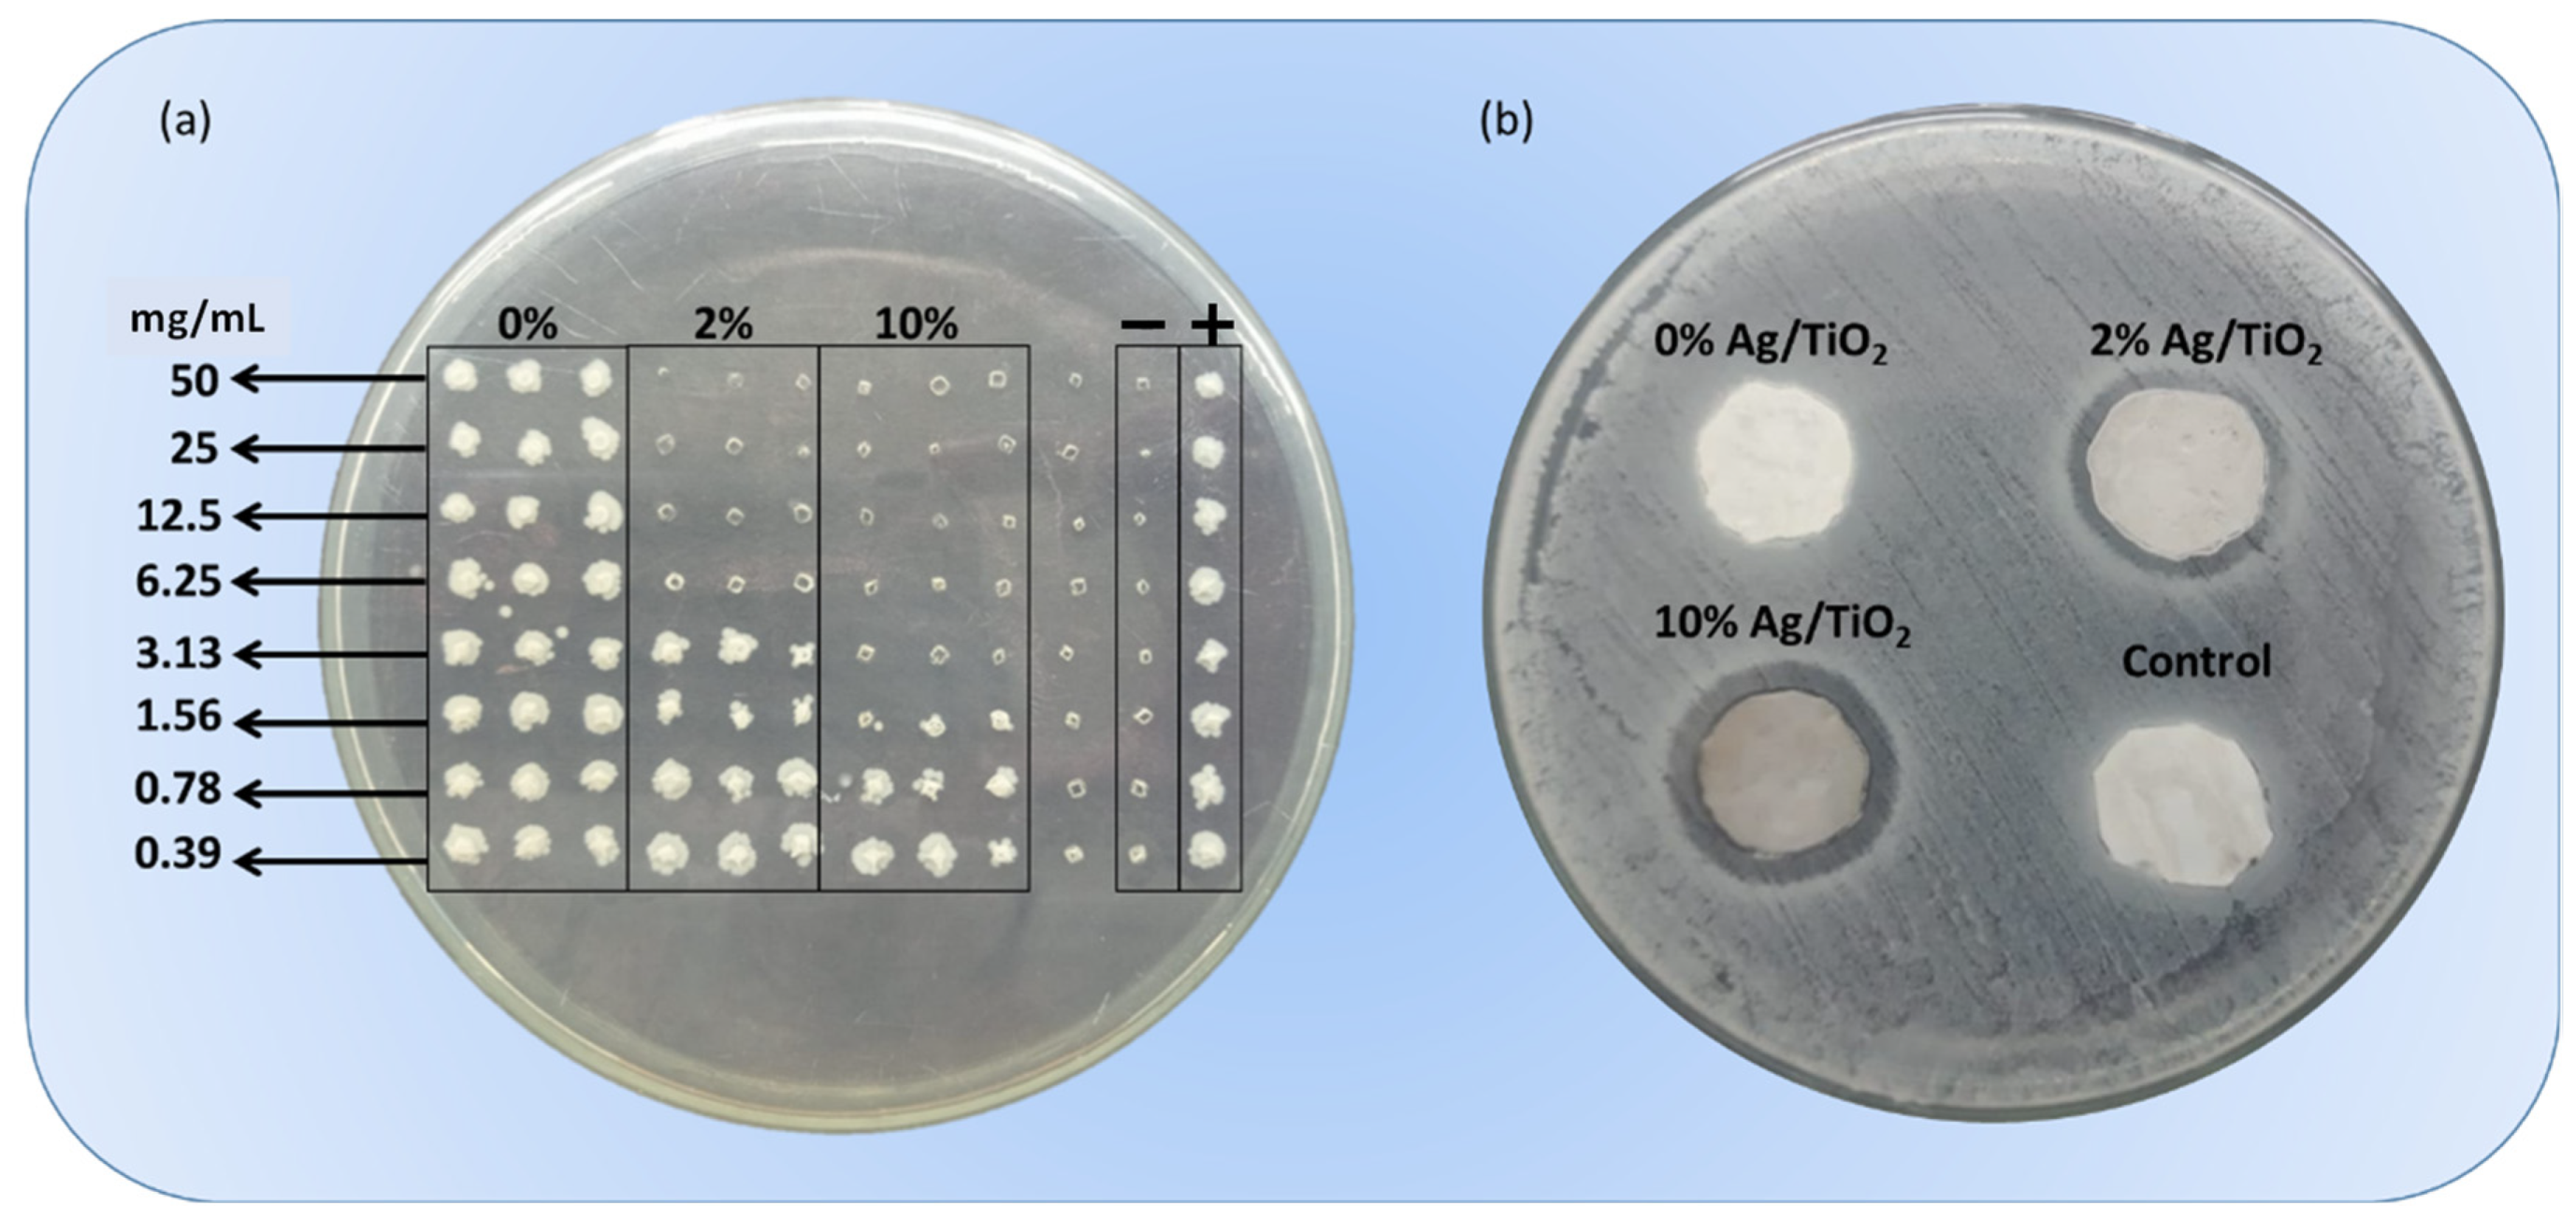
Applmicrobiol 03 00018 g004

Nile Tilapia Skin Impregnated with Antibacterial Silver/Titanium Dioxide Compounds
Abstract
:1. Introduction
2. Materials and Methods
2.1. Materials
2.2. Synthesis of Mixed Oxides
2.3. Tilapia Skin Treatment and Lyophilization
2.4. Impregnation of Mixed Oxides in Tilapia Skin
2.5. Characterization Techniques
2.6. Antibacterial Activity
2.7. Biofilm Formation and Counting Method
3. Results and Discussion
3.1. Characterization
3.2. Antibacterial Assays
4. Conclusions
Author Contributions
Funding
Institutional Review Board Statement
Informed Consent Statement
Data Availability Statement
Acknowledgments
Conflicts of Interest
References
- Loo, Y.Y.; Rukayadi, Y.; Nor-Khaizura, M.-A.; Kuan, C.H.; Chieng, B.W.; Nishibuchi, M.; Radu, S. In Vitro Antimicrobial Activity of Green Synthesized Silver Nanoparticles Against Selected Gram-negative Foodborne Pathogens. Front. Microbiol. 2018, 9, 1555. [Google Scholar] [CrossRef] [PubMed]
- De Saravia, S.G.G.; Rastelli, S.E.; Angulo-Pineda, C.; Palza, H.; Viera, M.R. Anti-adhesion and antibacterial activity of silver nanoparticles and graphene oxide-silver nanoparticle composites. Matéria 2020, 25, e-12771. [Google Scholar] [CrossRef]
- Rao, T.N.; Riyazuddin; Babji, P.; Ahmad, N.; Khan, R.A.; Hassan, I.; Shahzad, S.A.; Husain, F.M. Green synthesis and structural classification of Acacia nilotica mediated-silver doped titanium oxide (Ag/TiO2) spherical nanoparticles: Assessment of its antimicrobial and anticancer activity. Saudi J. Biol. Sci. 2019, 26, 1385–1391. [Google Scholar] [CrossRef] [PubMed]
- Deshmukh, S.P.; Mullani, S.B.; Koli, V.B.; Patil, S.M.; Kasabe, P.J.; Dandge, P.B.; Pawar, S.A.; Delekar, S.D. Ag Nanoparticles Connected to the Surface of TiO2 Electrostatically for Antibacterial Photoinactivation Studies. Photochem. Photobiol. 2018, 94, 1249–1262. [Google Scholar] [CrossRef] [PubMed]
- Lampé, I.; Beke, D.; Biri, S.; Csarnovics, I.; Csík, A.; Dombrádi, Z.; Hajdu, P.; Hegedűs, V.; Rácz, R.; Varga, I.; et al. Investigation of silver nanoparticles on titanium surface created by ion implantation technology. Int. J. Nanomed. 2019, 14, 4709–4721. [Google Scholar] [CrossRef]
- Gudkov, S.V.; Serov, D.A.; Astashev, M.E.; Semenova, A.A.; Lisitsyn, A.B. Ag2O Nanoparticles as a Candidate for Antimicrobial Compounds of the New Generation. Pharmaceuticals 2022, 15, 968. [Google Scholar] [CrossRef]
- Rajabi, A.; Ghazali, M.J.; Mahmoudi, E.; Baghdadi, A.H.; Mohammad, A.W.; Mustafah, N.M.; Ohnmar, H.; Naicker, A.S. Synthesis, Characterization, and Antibacterial Activity of Ag2O-Loaded Polyethylene Terephthalate Fabric via Ultrasonic Method. Nanomaterials 2019, 9, 450. [Google Scholar] [CrossRef]
- Yin, I.X.; Zhang, J.; Zhao, I.S.; Mei, M.L.; Li, Q.; Chu, C.H. The Antibacterial Mechanism of Silver Nanoparticles and Its Application in Dentistry. Int. J. Nanomed. 2020, 15, 2555–2562. [Google Scholar] [CrossRef]
- Ahmad, S.A.; Das, S.S.; Khatoon, A.; Ansari, M.T.; Afzal, M.; Hasnain, S.; Nayak, A.K. Bactericidal activity of silver nanoparticles: A mechanistic review. Mater. Sci. Energy Technol. 2020, 3, 756–769. [Google Scholar] [CrossRef]
- Kanakaraju, D.; Kutiang, F.D.A.; Lim, Y.C.; Goh, P.S. Recent progress of Ag/TiO2 photocatalyst for wastewater treatment: Doping, co-doping, and green materials functionalization. Appl. Mater. Today 2022, 27, 101500. [Google Scholar] [CrossRef]
- Yerli-Soylu, N.; Akturk, A.; Kabak, Ö.; Erol-Taygun, M.; Karbancioglu-Guler, F.; Küçükbayrak, S. TiO2 nanocomposite ceramics doped with silver nanoparticles for the photocatalytic degradation of methylene blue and antibacterial activity against Escherichia coli. Eng. Sci. Technol. Int. J. 2022, 35, 101175. [Google Scholar] [CrossRef]
- Mariappan, A.; Pandi, P.; Rajeswarapalanichamy, R.; Neyvasagam, K.; Sureshkumar, S.; Gatasheh, M.K.; Hatamleh, A.A. Bandgap and visible-light-induced photocatalytic performance and dye degradation of silver doped HAp/TiO2 nanocomposite by sol-gel method and its antimicrobial activity. Environ. Res. 2022, 211, 113079. [Google Scholar] [CrossRef]
- Andre, R.D.S.; Zamperini, C.A.; Mima, E.G.D.O.; Longo, V.M.; Albuquerque, A.; Sambrano, J.R.; Machado, A.L.; Vergani, C.; Hernandes, A.C.; Varela, J.A.; et al. Antimicrobial activity of TiO2:Ag nanocrystalline heterostructures: Experimental and theoretical insights. Chem. Phys. 2015, 459, 87–95. [Google Scholar] [CrossRef]
- Nigussie, G.Y.; Tesfamariam, G.M.; Tegegne, B.M.; Weldemichel, Y.A.; Gebreab, T.W.; Gebrehiwot, D.G.; Gebremichel, G.E. Antibacterial Activity of Ag-Doped TiO2 and Ag-Doped ZnO Nanoparticles. Int. J. Photoenergy 2018, 2018, 5927485. [Google Scholar] [CrossRef]
- Dias, H.B.; Bernardi, M.I.B.; Bauab, T.M.; Hernandes, A.C.; Rastelli, A.N.D.S. Titanium dioxide and modified titanium dioxide by silver nanoparticles as an anti biofilm filler content for composite resins. Dent. Mater. 2018, 35, e36–e46. [Google Scholar] [CrossRef] [PubMed]
- Chen, R.; Han, Z.; Huang, Z.; Karki, J.; Wang, C.; Zhu, B.; Zhang, X. Antibacterial activity, cytotoxicity and mechanical behavior of nano-enhanced denture base resin with different kinds of inorganic antibacterial agents. Dent. Mater. J. 2017, 36, 693–699. [Google Scholar] [CrossRef] [PubMed]
- Li, S.; Zhu, Q.; Sun, Y.; Wang, L.; Lu, J.; Nie, Q.; Ma, Y.; Jing, W. Fabrication of Ag Nanosheet@TiO2 Antibacterial Membranes for Inulin Purification. Ind. Eng. Chem. Res. 2020, 59, 7797–7804. [Google Scholar] [CrossRef]
- Chambers, C.; Stewart, S.; Su, B.; Jenkinson, H.; Sandy, J.; Ireland, A. Silver doped titanium dioxide nanoparticles as antimicrobial additives to dental polymers. Dent. Mater. 2016, 33, e115–e123. [Google Scholar] [CrossRef]
- Jiménez-Ramírez, A.J.; Martínez-Martínez, R.E.; Ayala-Herrera, J.L.; Zaragoza-Contreras, E.A.; Domínguez-Pérez, R.A.; Reyes-López, S.Y.; Donohue-Cornejo, A.; Cuevas-González, J.C.; Silva-Benítez, E.L.; Espinosa-Cristóbal, L.F. Antimicrobial Activity of Silver Nanoparticles against Clinical Biofilms from Patients with and without Dental Caries. J. Nanomater. 2021, 2021, 5587455. [Google Scholar] [CrossRef]
- Gao, L.; Gan, W.; Xiao, S.; Zhan, X.; Li, J. A robust superhydrophobic antibacterial Ag–TiO2 composite film immobilized on wood substrate for photodegradation of phenol under visible-light illumination. Ceram. Int. 2016, 42, 2170–2179. [Google Scholar] [CrossRef]
- Uhm, S.-H.; Song, D.-H.; Kwon, J.-S.; Lee, S.-B.; Han, J.-G.; Kim, K.-N. Tailoring of antibacterial Ag nanostructures on TiO2nanotube layers by magnetron sputtering. J. Biomed. Mater. Res. Part B: Appl. Biomater. 2013, 102, 592–603. [Google Scholar] [CrossRef] [PubMed]
- Muflikhun, M.A.; Chua, A.Y.; Santos, G.N.C. Structures, Morphological Control, and Antibacterial Performance of Ag/TiO2 Micro-Nanocomposite Materials. Adv. Mater. Sci. Eng. 2019, 2019, 9821535. [Google Scholar] [CrossRef]
- Qais, F.A.; Shafiq, A.; Khan, H.M.; Husain, F.M.; Khan, R.A.; Alenazi, B.; Alsalme, A.; Ahmad, I. Antibacterial Effect of Silver Nanoparticles Synthesized Using Murraya koenigii (L.) against Multidrug-Resistant Pathogens. Bioinorg. Chem. Appl. 2019, 2019, 4649506. [Google Scholar] [CrossRef] [PubMed]
- Durdu, S.; Aktug, S.L.; Korkmaz, K.; Yalcin, E.; Aktas, S. Fabrication, characterization and in vitro properties of silver-incorporated TiO2 coatings on titanium by thermal evaporation and microarc oxidation. Surf. Coatings Technol. 2018, 352, 600–608. [Google Scholar] [CrossRef]
- Thukkaram, M.; Cools, P.; Nikiforov, A.; Rigole, P.; Coenye, T.; Van Der Voort, P.; Du Laing, G.; Vercruysse, C.; Declercq, H.; Morent, R.; et al. Antibacterial activity of a porous silver doped TiO2 coating on titanium substrates synthesized by plasma electrolytic oxidation. Appl. Surf. Sci. 2019, 500, 144235. [Google Scholar] [CrossRef]
- Amjad, U.-E.; Lenzi, G.G.; Fernandes-Machado, N.R.C.; Specchia, S. MgO and Nb2O5 oxides used as supports for Ru-based catalysts for the methane steam reforming reaction. Catal. Today 2015, 257, 122–130. [Google Scholar] [CrossRef]
- Colpini, L.M.S.; Lenzi, G.G.; Urio, M.B.; Kochepka, D.M.; Alves, H.J. Photodiscoloration of textile reactive dyes on Ni/TiO2 prepared by the impregnation method: Effect of calcination temperature. J. Environ. Chem. Eng. 2014, 2, 2365–2371. [Google Scholar] [CrossRef]
- Elshahawy, A.M.; Mahmoud, G.A.-E.; Mokhtar, D.M.; Ibrahim, A. The optimal concentration of silver nanoparticles in sterilizing fish skin grafts. Sci. Rep. 2022, 12, 19483. [Google Scholar] [CrossRef]
- Ibrahim, A.; Soliman, M.; Kotb, S.; Ali, M.M. Evaluation of fish skin as a biological dressing for metacarpal wounds in donkeys. BMC Veter-Res. 2020, 16, 472. [Google Scholar] [CrossRef]
- Guimarães, M.L.; da Silva, F.A.G.; da Costa, M.M.; de Oliveira, H.P. Coating of conducting polymer-silver nanoparticles for antibacterial protection of Nile tilapia skin xenografts. Synth. Met. 2022, 287, 117055. [Google Scholar] [CrossRef]
- Júnior, E.M.L.; Filho, M.O.D.M.; Costa, B.A.; Alves, A.P.N.N.; De Moraes, M.E.A.; Uchôa, A.M.D.N.; Martins, C.B.; Bandeira, T.D.J.P.G.; Rodrigues, F.A.R.; Paier, C.R.K.; et al. Lyophilised tilapia skin as a xenograft for superficial partial thickness burns: A novel preparation and storage technique. J. Wound Care 2020, 29, 598–602. [Google Scholar] [CrossRef] [PubMed]
- Tognetti, L.; Pianigiani, E.; Ierardi, F.; Mariotti, G.; Perotti, R.; Di Lonardo, A.; Rubegni, P.; Fimiani, M. Current insights into skin banking: Storage, preservation and clinical importance of skin allografts. J. Biorepository Sci. Appl. Med. 2017, 5, 41–56. [Google Scholar] [CrossRef]
- Wang, T.; Yang, L.; Wang, G.; Han, L.; Chen, K.; Liu, P.; Xu, S.; Li, D.; Xie, Z.; Mo, X.; et al. Biocompatibility, hemostatic properties, and wound healing evaluation of tilapia skin collagen sponges. J. Bioact. Compat. Polym. 2020, 36, 44–58. [Google Scholar] [CrossRef]
- Howaili, F.; Mashreghi, M.; Shahri, N.M.; Kompany, A.; Jalal, R. Development and evaluation of a novel beneficent antimicrobial bioscaffold based on animal waste-fish swim bladder (FSB) doped with silver nanoparticles. Environ. Res. 2020, 188, 109823. [Google Scholar] [CrossRef]
- Bhat, V.; John, N.; Shetty, A.; Raj, V.; Joseph, S.; Kuriakose, R.; Hameed, S. Assessment of Flexural Strength and Cytotoxicity of Heat Cure Denture Base Resin Modified with Titanium Dioxide Nanoparticles: An In Vitro Study. J. Contemp. Dent. Pr. 2021, 22, 1025–1029. [Google Scholar] [CrossRef]
- Neta, I.A.B.; Mota, M.F.; Lira, H.L.; Neves, G.A.; Menezes, R.R. Nanostructured titanium dioxide for use in bone implants: A short review. Cerâmica 2020, 66, 440–450. [Google Scholar] [CrossRef]
- Guimarães, M.L.; da Silva, F.A.G.; de Souza, A.M.; da Costa, M.M.; de Oliveira, H.P. All-green wound dressing prototype based on Nile tilapia skin impregnated with silver nanoparticles reduced by essential oil. Appl. Nanosci. 2021, 12, 129–138. [Google Scholar] [CrossRef]
- Ibrahim, A.; Hassan, D.; Kelany, N.; Kotb, S.; Soliman, M. Validation of Three Different Sterilization Methods of Tilapia Skin Dressing: Impact on Microbiological Enumeration and Collagen Content. Front. Veter-Sci. 2020, 7, 597751. [Google Scholar] [CrossRef]
- Wijnhoven, S.W.; Peijnenburg, W.J.; Herberts, C.A.; Hagens, W.I.; Oomen, A.G.; Heugens, E.H.; Roszek, B.; Bisschops, J.; Gosens, I.; Van De Meent, D.; et al. Nano-silver—A review of available data and knowledge gaps in human and environmental risk assessment. Nanotoxicology 2009, 3, 109–138. [Google Scholar] [CrossRef]
- Nie, Y.; Chen, J.; Xu, J.; Zhang, Y.; Yang, M.; Yang, L.; Wang, X.; Zhong, J. Vacuum freeze-drying of tilapia skin affects the properties of skin and extracted gelatins. Food Chem. 2021, 374, 131784. [Google Scholar] [CrossRef]
- da Silva, F.A.G.; Eckhart, K.E.; da Costa, M.M.; Sydlik, S.A.; de Oliveira, H.P. Inhibition of biofilm formation induced by functional graphenic materials impregnated in Nile tilapia (Oreochromis niloticus) skin. Appl. Surf. Sci. 2022, 576, 151768. [Google Scholar] [CrossRef]
- CLSI. Performance Standards for Antimicrobial Susceptibility Testing, 29th ed.; CLSI Supplement M100; Clinical and Laboratory Standards Institute: Wayne, PA, USA, 2019; p. 296. [Google Scholar]
- Alsharaeh, E.H.; Bora, T.; Soliman, A.; Ahmed, F.; Bharath, G.; Ghoniem, M.G.; Abu-Salah, K.M.; Dutta, J. Sol-Gel-Assisted Microwave-Derived Synthesis of Anatase Ag/TiO2/GO Nanohybrids toward Efficient Visible Light Phenol Degradation. Catalysts 2017, 7, 133. [Google Scholar] [CrossRef]
- Safaei, M.; Taran, M. Optimal conditions for producing bactericidal sodium hyaluronate-TiO2 bionanocomposite and its characterization. Int. J. Biol. Macromol. 2017, 104, 449–456. [Google Scholar] [CrossRef] [PubMed]
- Chelli, V.R.; Chakraborty, S.; Golder, A.K. Ag-doping on TiO2 using plant-based glycosidic compounds for high photonic efficiency degradative oxidation under visible light. J. Mol. Liq. 2018, 271, 380–388. [Google Scholar] [CrossRef]
- León, A.; Reuquen, P.; Garín, C.; Segura, R.; Vargas, P.; Zapata, P.; Orihuela, P.A. FTIR and Raman Characterization of TiO2 Nanoparticles Coated with Polyethylene Glycol as Carrier for 2-Methoxyestradiol. Appl. Sci. 2017, 7, 49. [Google Scholar] [CrossRef]
- Yang, C.; Zhang, H.; Gu, W.; Chen, C. Preparation and mechanism investigation of highly sensitive humidity sensor based on Ag/TiO2. Curr. Appl. Phys. 2022, 43, 57–65. [Google Scholar] [CrossRef]
- Desiati, R.D.; Taspika, M.; Sugiarti, E. Effect of calcination temperature on the antibacterial activity of TiO2/Ag nanocomposite. Mater. Res. Express 2019, 6, 095059. [Google Scholar] [CrossRef]
- Ganapathy, M.; Senthilkumar, N.; Vimalan, M.; Jeysekaran, R.; Potheher, I.V. Studies on optical and electrical properties of green synthesized TiO2@Ag core-shell nanocomposite material. Mater. Res. Express 2018, 5, 045020. [Google Scholar] [CrossRef]
- Kim, Y.E.; Kim, B.; Lee, W.; Na Ko, Y.; Youn, M.H.; Jeong, S.K.; Park, K.T.; Oh, J. Highly tunable syngas production by electrocatalytic reduction of CO2 using Ag/TiO2 catalysts. Chem. Eng. J. 2020, 413, 127448. [Google Scholar] [CrossRef]

Disclaimer/Publisher’s Note: The statements, opinions and data contained in all publications are solely those of the individual author(s) and contributor(s) and not of MDPI and/or the editor(s). MDPI and/or the editor(s) disclaim responsibility for any injury to people or property resulting from any ideas, methods, instructions or products referred to in the content. |
© 2023 by the authors. Licensee MDPI, Basel, Switzerland. This article is an open access article distributed under the terms and conditions of the Creative Commons Attribution (CC BY) license (https://creativecommons.org/licenses/by/4.0/).
Share and Cite
Marcolino, M.C.; Guimarães, M.L.; Fotius, J.A.A.; Colpini, L.M.S.; da Costa, M.M.; de Oliveira, H.P. Nile Tilapia Skin Impregnated with Antibacterial Silver/Titanium Dioxide Compounds. Appl. Microbiol. 2023, 3, 265-275. https://doi.org/10.3390/applmicrobiol3010018
Marcolino MC, Guimarães ML, Fotius JAA, Colpini LMS, da Costa MM, de Oliveira HP. Nile Tilapia Skin Impregnated with Antibacterial Silver/Titanium Dioxide Compounds. Applied Microbiology. 2023; 3(1):265-275. https://doi.org/10.3390/applmicrobiol3010018
Chicago/Turabian StyleMarcolino, Maíra Cristina, Milena Lima Guimarães, Jorge Alexandre Alencar Fotius, Leda Maria Saragiotto Colpini, Mateus Matiuzzi da Costa, and Helinando Pequeno de Oliveira. 2023. "Nile Tilapia Skin Impregnated with Antibacterial Silver/Titanium Dioxide Compounds" Applied Microbiology 3, no. 1: 265-275. https://doi.org/10.3390/applmicrobiol3010018
APA StyleMarcolino, M. C., Guimarães, M. L., Fotius, J. A. A., Colpini, L. M. S., da Costa, M. M., & de Oliveira, H. P. (2023). Nile Tilapia Skin Impregnated with Antibacterial Silver/Titanium Dioxide Compounds. Applied Microbiology, 3(1), 265-275. https://doi.org/10.3390/applmicrobiol3010018

